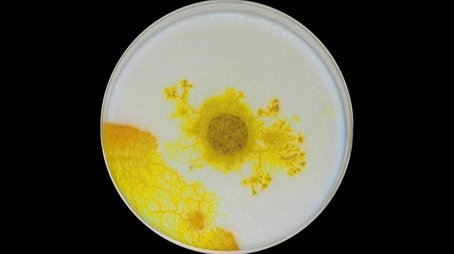

📢 Affiliate Disclosure
PlotSpoiler.com is a participant in the Amazon Services LLC Associates Program, an affiliate advertising program designed to provide a means for sites to earn advertising fees by advertising and linking to Amazon.com. When you click on affiliate links on our site and make a purchase, we may earn a commission at no additional cost to you. These commissions help support the operation and maintenance of our site.